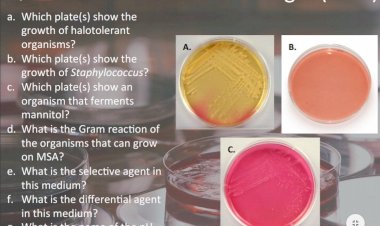
Question on MSA

Discussion
Regression Test was Conducted to Check Relationship of...
Regression Test was Conducted to Check Relationship of COR & Revenue. Pl draw Inference
Please identify the test that you would need to perform:
Please identify the test that you would need to perform